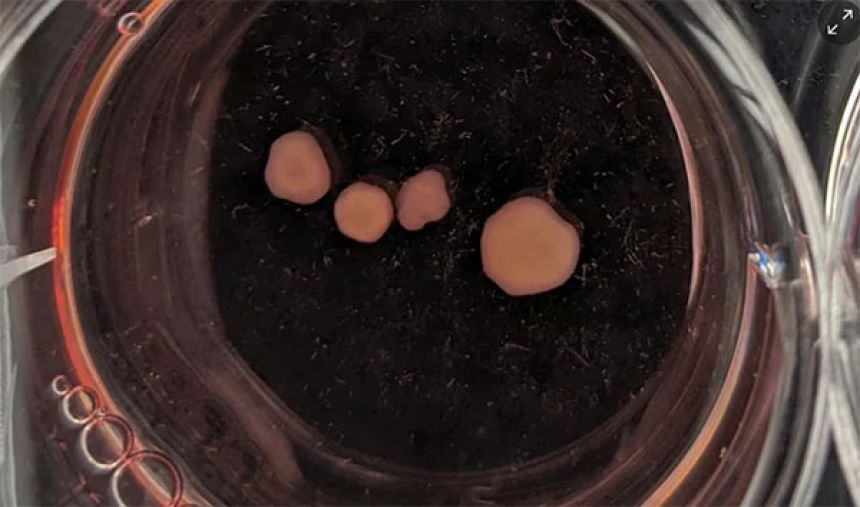

この画像を大きなサイズで見る
この画像を大きなサイズで見るその薄暗い部屋に足を踏みれれば、何やら幽玄な響きを耳にすることになる。
ガラガラ、ブーン、サラサラ……この形容し難い音はどこかあの世の楽団がチューニングでもしているかのようだ。
その音がこの世のものと思えぬのは、ある意味当然かもしれない。なぜならそれは、4年前に亡くなったアメリカの音楽家、アルヴィン・ルシエ氏の血液から作った脳オルガノイド(ミニ脳)なのだ。
脳オルガノイドに転生した作曲家
アメリカの音楽家アルヴィン・ルシエ氏が亡くなってから4年。彼の脳は、今も西オーストラリア州立美術館(AGWA)で音楽を生み出している。
人工的に育てられた脳の組織が、リアルタイムで音を作り出すこのイベント「Revivification(リヴィヴィフィケーション:復活)」は、芸術と科学、そして生と死の境界を問い直す試みだ。
AIとバイオテクノロジーが融合したこの前代未聞のインスタレーションは、「創造性とは何か」「作者とは誰か」といった根源的な問いを投げかける。
この試みを行ったのは、ネイサン・トンプソン氏、ガイ・ベン=アリ氏、マット・ギンゴールド氏、スチュアート・ホッジェッツ氏ら4人組の生物学的アート・グループだ。
もともと故アルヴィン・ルシエ氏は前衛的な音楽家で、1950年から単なる音楽ではなく、さまざまな技術を利用した作品を手掛けてきた。
代表作としては、1965年に発表された世界初となる脳波を用いたライブサウンドがある。
トンプソン氏らは、彼の長年のファンで、2018年から一緒にさまざまな構想を練ってきたのだという。
そして2020年、89歳のルシエ氏はパーキンソン病を患い、自らの血液を提供することに同意した。
プロジェクトチームは、ハーバード大学医学部の協力を得て、ルシエ氏の白血球から幹細胞を作成。
この幹細胞は、体内のあらゆる細胞に分化できる特性を持つ。そこから脳オルガノイド(ミニ脳)と呼ばれる、人間の発達中の脳に似た細胞の塊を成長させた。
この白い塊が、亡くなって4年たった今でも音楽を作り続けているのだ。
ルシエ氏の頭から取り出した脳そのものではないが、その神経細胞は頭蓋骨内の脳と同じように機能する。
この画像を大きなサイズで見る
この画像を大きなサイズで見る死後も音を生み出す脳オルガノイド
作品はRevivificationのチームとルシエ氏が共同で作り出したものだ。
おりしも新型コロナが猛威を振るっていた時期で、ルシエの体調も優れなかった。それでも2021年に彼が亡くなるまで、チームとルシエ氏はZoomで連絡を取り合い、意見が交わされた。
当初、ルシエ氏は音波を月へ送るという幻想的なアイデアを口にしていたが、最終的に、彼とチームが生涯をかけて追い求めた神経シグナル・音・空間をテーマにした作品を作ることになった。
ルシエ氏の血液から作られた脳オルガノイドは、西オーストラリア州立美術館の展示室の中央にある台座の上に設置された電極メッシュの上で育てられている。
そしてその電気信号が、部屋に配置された20枚の真鍮製のプレートに接続されたマレット(打楽器用のばち)を動かし、音を鳴らす仕組みになっている。つまり、脳の電気活動がそのまま音楽になるインスタレーションなのだ。
来場者はこの“脳”が発する電気信号によって生まれる音を聴くだけでなく、展示空間の音がマイクで拾われ、それが脳に電気信号として送り返されるという、音のやりとりが成立する仕組みも体験できる。
ベン=アリ氏は、「脳オルガノイドが時間とともに変化や学習したりするか、ぜひとも知りたいです」と語る。
 この画像を大きなサイズで見る
この画像を大きなサイズで見る芸術が科学の限界を押し広げる
Revivificationはあくまで芸術作品だ。だが同時に「創造性はどこに宿るのか」という科学的な疑問をも投げかけている。
「創造性は人間の身体の外に存在し得るのでしょうか? そうだとしても、それは倫理的なことなのでしょうか?」と、トンプソン氏。
この作品はその答えを示したりはしない。Revivificationチームが願うのは、むしろ対話のきっかけになることだ。あるいは、この作品で収集された膨大な神経データが、将来の科学研究の手助けになることもあるかもしれない。
将来的には、南極のような過酷な場所で実験したり、あるいは宇宙に打ち上げたりと、少々過激な構想もあるとのこと。
今は暗いギャラリーで黙々と新たな曲を作り続ける脳の姿をした作曲家だが、いずれは広い世界に連れ出され、深淵なる問いに答えるようになるのかもしれない。
まさに、死後も生きる音楽と呼ぶにふさわしい体験が提供されている「Revivification」は8月3日まで西オーストラリア美術館で開催される予定なので、興味のある人はぜひ足を運んでみて欲しい。
2025/04/30(追記) オルカノイドをオルガノイドに変更して再送します。
References: The composer still making music four years after his death – thanks to an artificial brain / Musician Who Died in 2021 Resurrected as Clump of Brain Matter, Now Composing New Music / Artgallery.wa.gov.au

















近い将来、我々は不老不死の夢を実現するのかも知れない
しかしその姿は、我々がかつて望んだものとは大きく異なっている・・・
タイトル、章タイトル、本文での一部で「オルカノイド」とあるが、正しくは「オルガノイド」。
死後であることは重要じゃないな
冷静に読むと意味がさっぱりわからん?
本人の希望がなかったら恐ろしいと思ったのですが、本人も生成に協力していたんだと別のところで安心しました
生かすだけで、育まれていない
人間の知恵や意志や魂が入り込む余地のない清純な音を奏でている究極的な作曲スタイルじゃねこれ
生前のルシエ氏も、没後のルシア氏も別の意味で憧れるな
どういうものであれ、生きている細胞であれば必ず何らかの活動をしているわけで、その活動らを情報としてピックアップして何らかの装置を通し、音楽めいた音として出力しているもよう
だとすれば……興味深い実験ではありますが、「作曲している」ということになるのでしょうか
今のところは風変わりな現代アートに過ぎないわけか
これが可能ならジョン・ウィリアムズと久石譲も頼みたい…